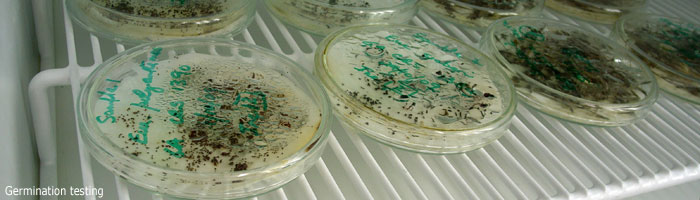
seed testing

Horticultural Research in the Gardens
- External Research Projects undertaken in the Australian National Botanic Gardens.
- Application for permits to remove plants from the Gardens or for research projects in the Gardens.
- Native Grass Restoration in the Australian Capital Territory Water Catchment - by Iain Dawson and Susan Winder.
- Grafting Australian Native Plants - a review of available data, by Iain Dawson.
- Plant Hardiness Zones for Australia - a review of the data and comparison with the US system, by Iain Dawson.
- Collecting, growing, and researching sub-Antarctic plants - Article 1, Article 2, Article 3, 1988 project report.
- Australian native plants as commercial foods - research undetaken by CSIRO.
![Director of National Parks [logo]](../../../images/dnp_90px.gif)